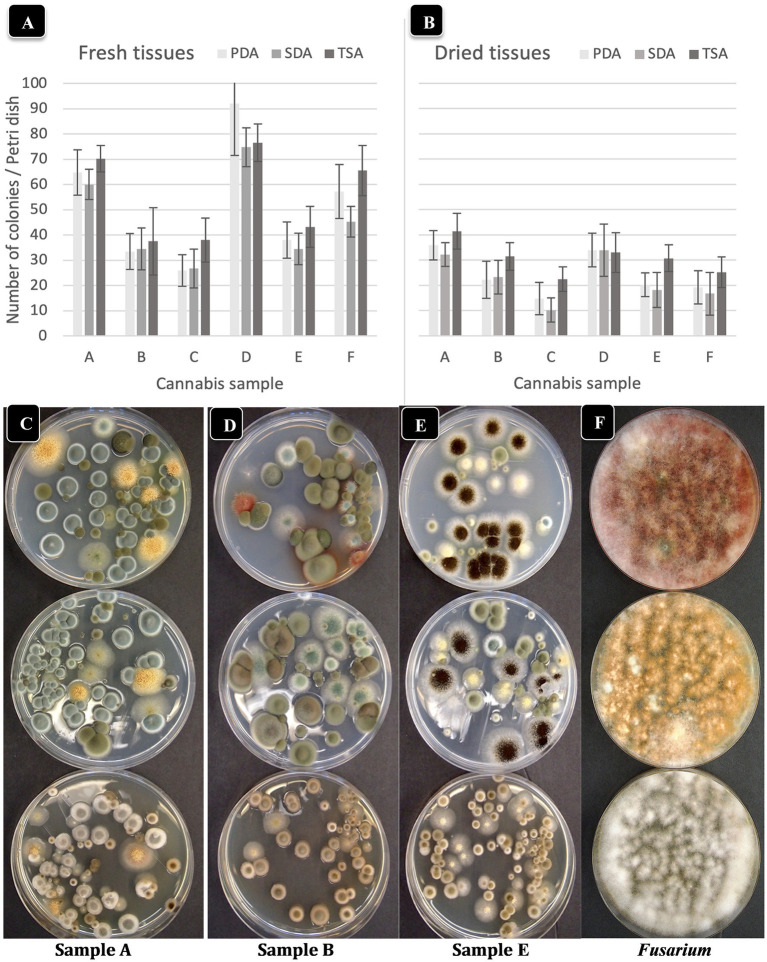
PMC10294073 – fig3
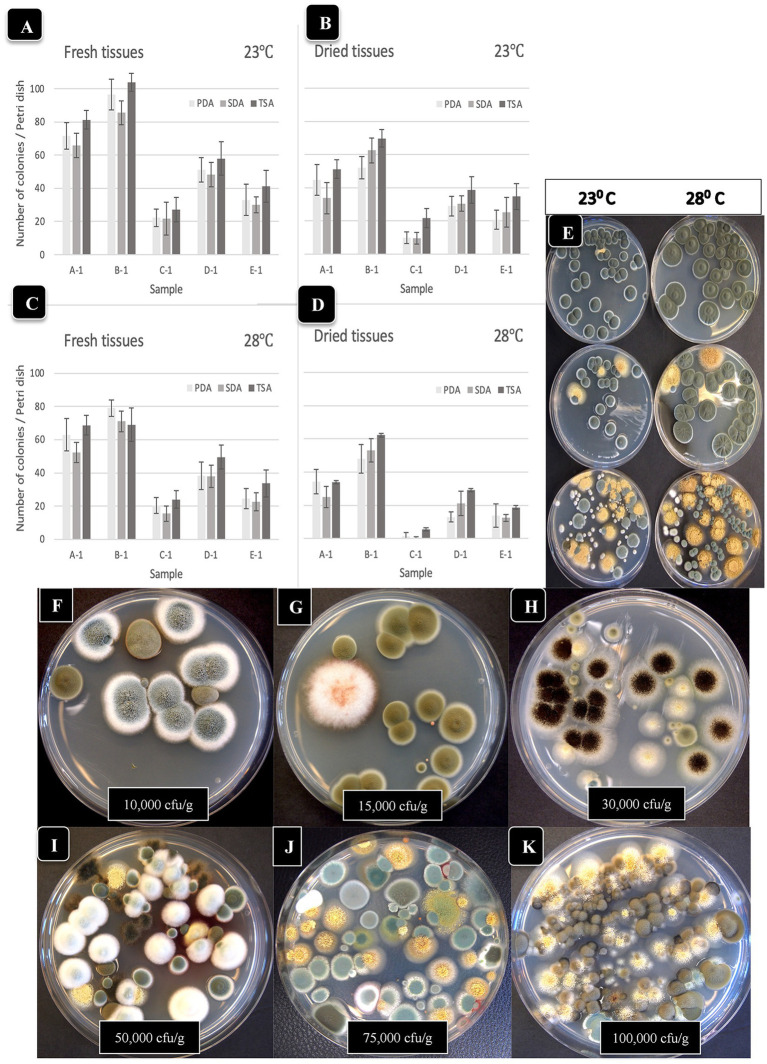
PMC10294073 – fig4
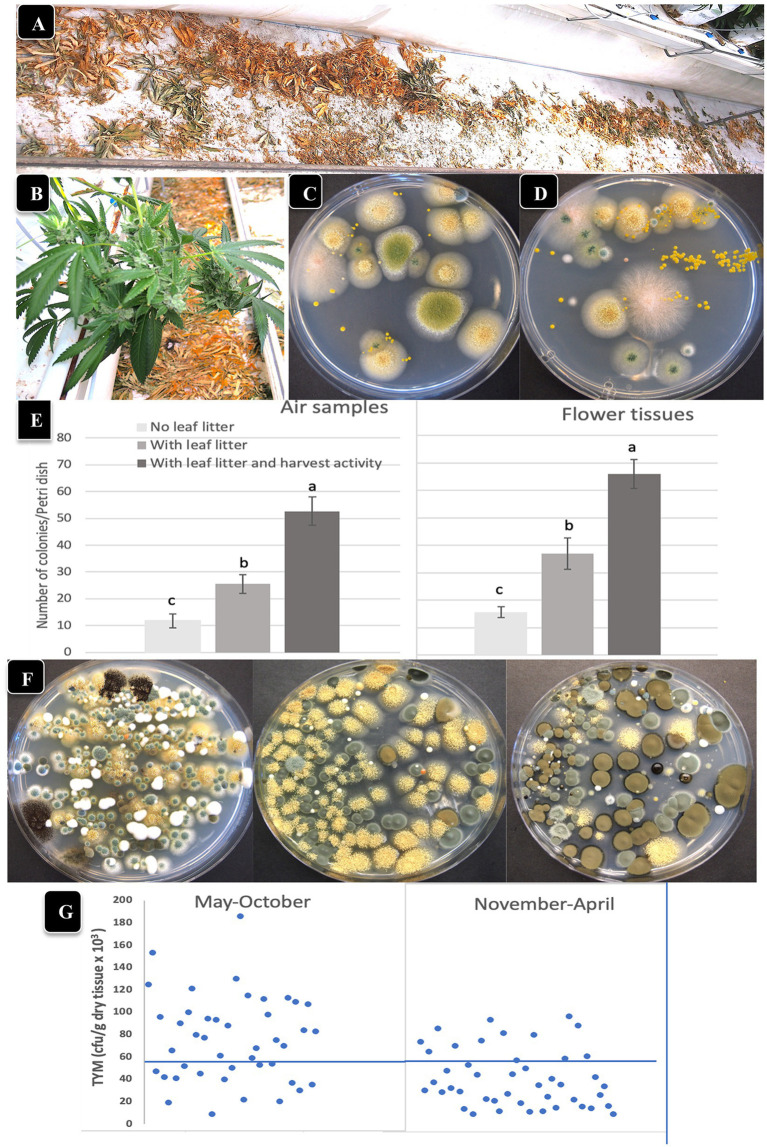
PMC10294073 – fig6
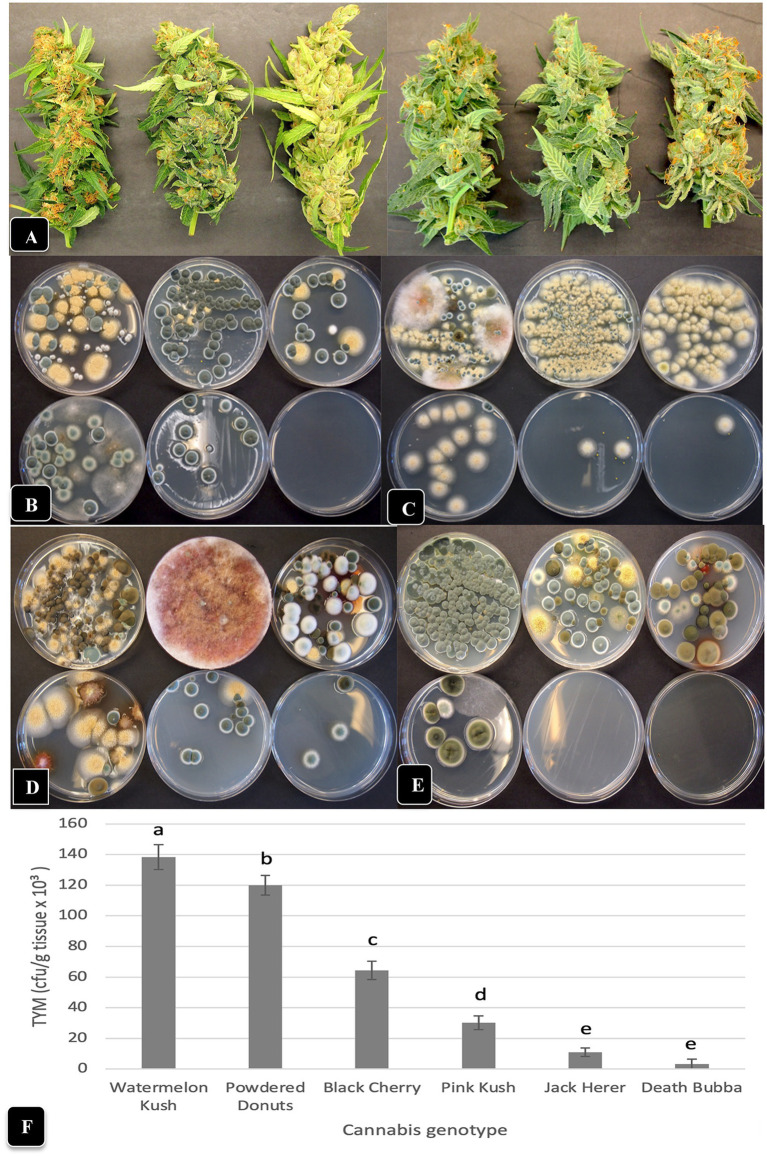
PMC10294073 – fig7
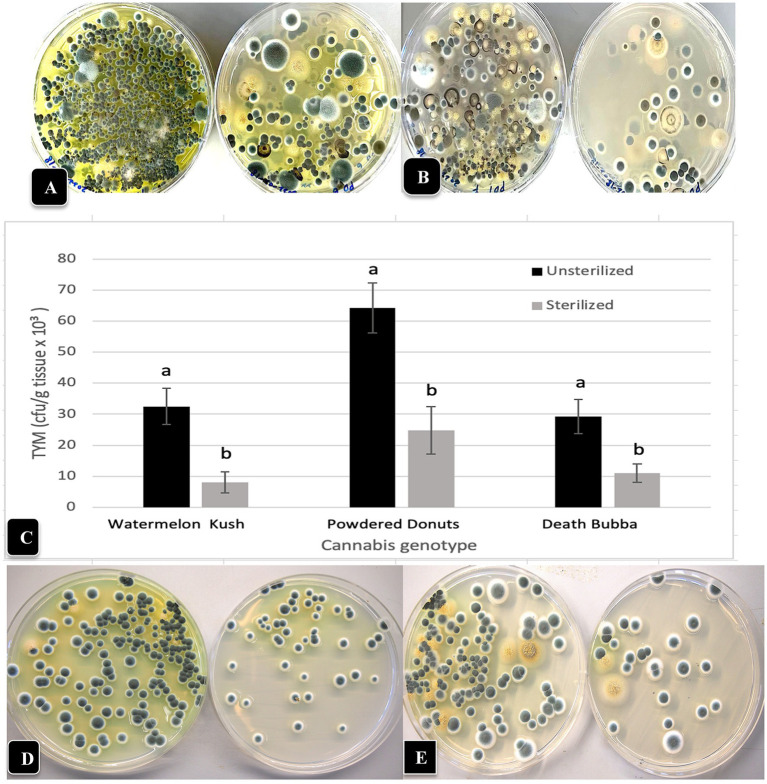
PMC10294073 – fig9

Total yeast and mold levels in high THC-containing cannabis (Cannabis sativa L.) inflorescences are influenced by genotype, environment, and pre-and post-harvest handling practices
Abstract
Total yeast and mold (TYM) levels in inflorescences of high THC-containing Cannabis sativa (cannabis) are regulated to ensure that medicinal and recreational users, especially those with immunocompromised systems, are not exposed to potentially harmful levels. In North America, the limits imposed range from 1,000–10,000 cfu/g of dried product to 50,000–100,000 cfu/g, depending on the jurisdiction. Factors affecting a build-up of TYM in cannabis inflorescences have not been previously researched. In this study, >2,000 fresh and dried samples were assayed for TYM over a 3-year period (2019–2022) to identify specific factors which can contribute to TYM levels. Greenhouse-grown inflorescences were sampled before and after commercial harvest, homogenized for 30 s, and plated onto potato dextrose agar (PDA) with 140 mg/L streptomycin sulfate. Colony-forming-units (cfu) were rated after 5 days of incubation at 23°C under 10–14 h light. PDA provided more consistent counts of cfu compared to Sabouraud dextrose and tryptic soy agars. The predominant fungal genera identified by PCR of the ITS1-5.8S-ITS2 region of rDNA were Penicillium, Aspergillus, Cladosporium, and Fusarium. In addition, four yeast genera were recovered. In total, 21 species of fungi and yeasts constituted the total cfu present in the inflorescences. The variables that significantly (p < 0.05) increased these TYM levels in inflorescences were: the genotype (strain) grown, presence of leaf litter in the greenhouse, harvesting activity by workers, genotypes with a higher abundance of stigmatic tissues and inflorescence leaves, higher temperature and relative humidity within the inflorescence microclimate, time of year (May–October), method of drying buds after harvest, and inadequate drying of buds. The variables which significantly (p < 0.05) decreased TYM in samples were: genotypes with lower numbers of inflorescence leaves, air circulation achieved by fans during inflorescence maturation, harvesting during November–April, hang-drying of entire inflorescence stems, and drying to a moisture content of 12–14% (water activity of 0.65–0.7) or lower which was inversely correlated with cfu levels. Under these conditions, the majority of dried commercial cannabis samples contained <1,000–5,000 cfu/g. Our findings indicate that TYM in cannabis inflorescences are the result of a dynamic interaction between genotype, environment, and post-harvest handling methods. Some of these factors may be altered by cannabis producers to reduce the potential build-up of these microbes. Among the 21 fungal and yeast species recovered from greenhouse-grown cannabis inflorescences, a few could pose a potential threat to human health, while many do not and they could provide beneficial interactions within the cannabis plant. The currently recommended plating methods onto agar media and enumeration of total cfu are unable to distinguish between these two groups.
Article type: Research Article
Keywords: mold, marijuana, microbes, contaminants, yeasts, microbiome, quality assurance
License: Copyright © Punja, Ni, Lung and Buirs. CC BY 4.0 This is an open-access article distributed under the terms of the Creative Commons Attribution License (CC BY). The use, distribution or reproduction in other forums is permitted, provided the original author(s) and the copyright owner(s) are credited and that the original publication in this journal is cited, in accordance with accepted academic practice. No use, distribution or reproduction is permitted which does not comply with these terms.
Article links: DOI: 10.3389/fmicb.2023.1192035 | PubMed: 37383630 | PMC: PMC10294073
Relevance: Relevant: mentioned in keywords or abstract
Full text: PDF (9.5 MB)
Introduction
Commercial production of drug-type Cannabis sativa L. (marijuana, cannabis) containing the psychoactive compound Δ9-tetrahydrocannabinol (also referred as Δ9-THC) takes place in indoor controlled environment growing spaces, in greenhouses and under field conditions. At present, a number of countries worldwide allow cannabis production for medical purposes, and some jurisdictions have approved the legal cultivation of cannabis for recreational use. The latter include countries such as Uruguay, Canada, and Thailand, as well as more than 20 individual states within the USA (ref. Punja, 2021a). The cannabis product is derived from large complex inflorescences (racemes) comprised of aggregate pistillate structures and are harvested after 7–8 weeks of flowering under controlled photoperiods (ref. Bernstein et al., 2019; ref. Naim-Feil et al., 2022). The inflorescences are dried to a moisture content of 12–14% before packaging for sale (ref. Caplan et al., 2022). All jurisdictions in which cannabis has been legally approved for medicinal and/or recreational use are required to test for the presence of total yeasts and mold (TYM) prior to sale, since these can potentially negatively affect immunocompromised patients (ref. Jameson et al., 2022). Additional testing for specific bacterial pathogens known to affect humans, e.g., Escherichia coli, Salmonella spp. and Staphylococcus aureus, is required, in addition to testing for pesticides and mycotoxins (ref. Boyar, 2021; ref. Pusiak et al., 2021; ref. Jameson et al., 2022). The microbial tests are conducted by licensed third-party laboratories and TYM presence is reported as colony-forming units per gram (cfu/g) of dried flowers (buds). The TYM limits imposed vary considerably by country and different jurisdictions, ranging from 1,000–10,000 cfu/g to higher limits of 50,000–100,000 cfu/g. In Canada, the limit is 50,000 cfu/g (ref. Anonymous, 2018; ref. Health Canada, 2019), while in the United States, it varies considerably by state.1
The results from TYM testing of cannabis samples submitted to commercial labs can vary considerably. The cfu counts may be influenced by the methods used, including the agar medium on which extracted samples are plated, the method of sample extraction, incubation time and temperature, the degree of sample dilution, and various other parameters that are discussed elsewhere (ref. Tournas et al., 2001; ref. Boyar, 2021; ref. McKernan et al., 2021; ref. Repay, 2021; ref. Curry, 2022). In contrast, factors such as the origins of the sample, i.e., cannabis strain (genotype), growing conditions, and method of post-harvest handling, and their impact on potential TYM levels, have not been previously investigated. Sample origin is a biologically relevant variable that can potentially influence levels of TYM in the final product and is an important aspect that has been under-studied due to the complexity of identifying numerous and different variables in the cannabis growing environment and gaining access to a facility to perform such work. With the exception of DNA-based tests specifically designed to detect Aspergillus species, the TYM current testing does not identify specific species of fungi nor confirm presence/absence of other potentially toxigenic fungi, such as Fusarium and Penicillium, that can be present on dried cannabis (ref. Punja, 2021b).
In this study, we sampled cannabis inflorescences in a commercial greenhouse environment at various times over a 3-year period to identify factors that could contribute to a build-up of TYM. We first describe the influence of nutrient agar media on recovery of TYM, and then compare different cannabis genotypes, time of sampling, sample source, post-harvest handling method, and extent of drying on the colony forming units of yeast and mold recovered. We also identified the most prevalent genera and species of yeast and mold recovered from these samples using molecular methods. Our findings point to cannabis genotype, production methods and post-harvest handling practices as having a significant impact on TYM in cannabis based on an analysis of >2,000 samples in this study.
Materials and methods
Plant materials
This research project was conducted in a Health Canada-approved licensed commercial facility in which all cannabis plants were grown using a hydroponic method of cultivation (ref. Punja, 2021c). A range of different genotypes (strains) were grown under greenhouse conditions during the fall–winter months (October–April) and spring–summer months (May–September) over a 3-year period (2019–2022), which generally included four cropping cycles per year (Figure 1). These genotypes represented the most frequently grown at the time of sampling and are described in Table 1 and illustrated in Figure 2. During the winter period, plants were provided with supplementary lighting to achieve approximately 1,600 uEin/m2 of photosynthetically active radiation (PAR) using high pressure sodium lamps emitting a wavelength centered at 590 nm. During the summer period, supplementary lighting was provided where needed on overcast days to achieve the required PAR.

Table 1: Phenotypic characteristics of six cannabis genotypes used in the present study.
| Phenotypic trait | Watermelon Kush | Pink Kush | Powdered Donuts | Jack Herer | Black Cherry | Death Bubba |
|---|---|---|---|---|---|---|
| Total yeast and mold levels | High | Moderate | High | Low | Moderate | Low |
| Botrytis cinerea susceptibility | High (>5% infection) | High (>5% infection) | High (>5% infection) | Low (<1% infection) | Low (<1% infection) | Low (<1% infection) |
| Powdery mildew susceptibility | Unknown | High | High | Unknown | Low-medium | Low |
| THC range | <17% | 19–25% | 20–28% | <17% | 19–25% | 17–23% |
| CBD range | 0–1% | 0–1% | 0–1% | 0–1% | 0–1% | 0–1% |
| Top five terpenes (highest to lowest) | Unknown | Caryophyllene Bisabolol Humulene Linalool Myrcene | Caryophyllene Myrcene Limonene Linalool Humulene | Unknown | Caryophyllene Limonene Linalool Myrcene Bisabolol | Caryophyllene Humulene Myrcene Limonene Bisabolol |
| Genotype characteristic | Indica | Indica | Hybrid | Sativa | Indica | Indica |

All plants were initiated from vegetative cuttings taken from stock (mother) plants of various genotypes grown under greenhouse conditions with a temperature range of 23–28°C and relative humidity of 60–70%. The cuttings were dipped in a rooting powder (containing indoleacetic acid) and inserted into 2.5 cm3 rockwool cubes, which were then placed in trays in a propagation room under high relative humidity (80–90%) and a temperature range of 23–27°C. After 2 weeks, when cuttings had rooted, they were placed into wells cut into 10 cm3 rockwool blocks and transferred to a greenhouse bench for an additional 2 weeks to acclimatize and resume vegetative growth. Following this, they were placed on large cocofibre blocks, one plant per block, and transferred to a large flowering room. After 1 week of growth, the photoperiod was adjusted to 12 h lighting:12 h darkness to induce flowering (ref. Punja, 2021a). The water and nutrient regimes were provided according to commercial growing requirements to ensure optimal growth. The plants were arranged in rows up to 104 m in length containing 216 plants, with 2 rows parallel to each other, and spacing of 0.5 m between plants. Each greenhouse compartment contained up to 27 rows of plants, which were separated by a 1 m wide walkway between rows. The plants were trained and supported by plastic mesh netting that ensured the developing inflorescences remained upright (Figures 1A,B). Pruning of leaves and training of plants were conducted manually according to commercial growing requirements as needed. Plants were grown for 7–8 weeks in the flowering period in each cropping cycle and then harvested. All stems bearing inflorescences were removed manually and the individual flower buds were detached from the stems prior to drying on racks, or the buds were detached after hang drying of the entire stem. Drying was conducted in controlled environment rooms set at 21–23°C and 50–55% relative humidity for 5–7 days.
Sample source
For analysis of total yeast and mold levels (TYM) in this study, all inflorescence samples were obtained from plants in the final 2 weeks of flower (usually week 7 or 8 in the flowering period) representing different genotypes being grown (fresh samples) or following drying using the rack or hang dry procedure (dried samples). Fresh samples were obtained by randomly removing the terminal inflorescences from plants within selected rows in the greenhouse and placing them inside plastic bags, which were stored overnight at 5°C prior to processing the following morning. Samples were generally collected during the morning hours (from 10:00 am to 1:00 pm). Dried samples were randomly obtained from the drying rooms, with records made of the harvest date and genotype, and stored at room temperature inside plastic bags. All samples were collected in three replicates, each from a different plant for fresh samples, and labeled according to genotype and date of sampling. Samples were collected during the winter and summer growing seasons at various times (usually weekly) during the 3-year sampling period. For data analysis to determine the influence of different variables on TYM levels, the data from replicated samples were assessed using statistical methods as described below.
Determining total yeast and mold levels
The tissues used for TYM analysis included fresh and dried inflorescence samples as well as dried cannabis leaves. Samples of 10 gm of fresh tissue or 1 gm of dried tissues were homogenized in a Waring blender to which 100 mL of sterile distilled water was added and the mixture was blended at high speed for 30 s. A volume of 400 mL of water was added, stirred, and an aliquot of 0.5 mL was transferred to agar media and spread using a Q-tip. Three agar media were compared for frequency of recovery of yeasts and molds, colony characteristics, and uniformity across replicate dishes. These media included potato dextrose agar (Sigma-Aldrich Canada, Oakville, ON, Canada) to which 140 mg/L of streptomycin sulfate was added to inhibit bacterial growth (PDA + S), Sabouraud dextrose agar (Fisher Scientific Company, Ottawa, ON, Canada) and tryptic soy agar (Sigma-Aldrich, Oakville, ON, Canada). Duplicate samples of each tissue source were used for grinding and each sample was plated onto four replicate Petri dishes of each of the different media types (n = 8). One batch of dishes was incubated at ambient room temperature (21–23°C) and a duplicate set was placed in an incubator set at 28 ± 0.5°C and both sets were provided with 10–14 h/day of florescent lighting, to replicate flower room conditions. After 5 days, the Petri dishes were assessed for the total number of colonies and the size and morphology of the colonies were recorded. This procedure was repeated for multiple samples of cannabis collected at different times to ensure the consistency of the results. The mean number of colonies in each sample on each of the different media was determined and data are presented with the standard error of the mean (SE, n = 8). Morphological unique colonies were transferred to fresh dishes of PDA + S and following growth over 2 weeks, sub-cultured again to ensure purity, and then subjected to molecular identification as described below.
To compare the accuracy of the grinding and plating assay used in this study with analyses conducted by commercial laboratories that routinely conduct TYM assays, a replicated set of fresh and dried flower samples were subdivided into three sub-samples; two were sent to individual commercial laboratories located in Canada (their identity is kept anonymous). The third replicate was processed using the method described above. TYM counts per g of sample were compared for the three sub-samples. The process was repeated for dried leaf material that was collected from the greenhouse floor.
Morphological and molecular identification of TYM
To identify each morphologically unique colony to genus and species, a PCR method utilizing primers for the ITS1-5.8S-ITS2 region of ribosomal DNA (rDNA) was used (ref. Punja, 2021b). DNA was extracted from mycelium scraped from the surface of colonies on PDA + S using the QIAGEN DNeasy Plant Mini Kit. Aliquots of 1 μL containing 5–20 ng DNA were used for PCR in a 25 μL reaction volume consisting of 2.5 μL 10X buffer (containing 15 mM MgCl2), 0.5 μL 10 mM dNTP, 0.25 μL Taq DNA Polymerase (QIAGEN), 0.25 μL 10 mM forward and reverse primers, as well as 20.25 μL DNAse- and RNAse-free water (Invitrogen). The universal eukaryotic primers UN-UP18 S42 (5′-CGTAACAAGGTTTCCGTAGGTGAAC-3′) and UN-LO28 S576B (5′-GTTTCTTTTCCTCC GCTTATTAATATG-3′) were used (ref. Punja, 2021b,ref. c). All PCR amplifications were performed in a MyCycler thermocycler (BIORAD) with the following program: 3 min at 94°C; 30 s at 94°C, 30 s at 60°C, 3 min at 72°C (35 cycles); and 7 min at 72°C. PCR products were separated on 1% agarose gels and bands of the expected size (ca. 700 bp) were purified with QIAquick Gel Extraction Kit and sent to Eurofins Genomics (Eurofins MWG Operon LLC 2016, Louisville, KY) for sequencing. The resulting sequences were compared to the corresponding ITS1-ITS2 sequences from the National Centre for Biotechnology Information (NCBI) GenBank database to confirm species identity using only sequence identity values above 99%. A total of 450 fungal and yeast colonies were analyzed. Genbank accession numbers only for the unique fungal species recovered are presented in Supplementary Figure 1.
Air sampling for yeasts and molds
Air sampling was conducted in the greenhouse environment by placing Petri dishes containing PDA + S close to the inflorescences on plants where they were left with lids removed for 60 min (Figure 1). The sampling was mostly conducted between 11:00 a.m. and 2:00 p.m. The lids were replaced and the dishes were taken to the laboratory for identification of morphologically distinct colonies of fungal species as described above. A total of 500 Petri dishes were used at various times over the duration of this study to characterize the air-borne yeasts and molds. More than 200 individual colonies were selected and analyzed by PCR.
Influence of cannabis genotypes on TYM levels
To assess the potential influence of six cannabis genotypes on the presence of TYM in the inflorescences, fresh inflorescence samples were obtained and homogenized and plated at various times as described previously. To determine the influence of time of the year on populations of TYM, replicate samples from the six genotypes were collected from plants growing in June, July, August, and September of 2021 from sequentially harvested crops and plated onto PDA + S. Comparisons were made of the total number of colonies and types of fungi and yeast recovered from combined replicate samples of each genotype (n = 16).
To further determine the possible role of inflorescence leaves on TYM, five genotypes were selected for study. These were “Watermelon Kush”, “Powdered Donuts”, “Death Bubba”, “Pink Kush” and “Jack Herer” (genotype “Black Cherry” was unavailable). Terminal inflorescence stems measuring up to 15 cm in height were removed from the plants and brought back to the laboratory to be analyzed. All leaves emerging from the inflorescences, which included large multi-foliate fan leaves and single unifoliate leaves, were carefully dissected using a scalpel and counted from five replicate samples. To determine the TYM levels in these tissues, 10 g of fan leaves or unifoliate leaves were homogenized and plated onto PDA + S. Colony counts were made after 5 days of incubation (n = 20). The experiment was conducted three times. The mean number of inflorescence leaves in each genotype and the TYM colonies derived from each sample were averaged and expressed with the standard error of the mean (SE, n = 20). To determine if surface-sterilization of inflorescence leaves had an impact on the TYM recovered, dissected leaves from three genotypes were immersed in 0.625% NaOCl for 1 min followed by 70% EtOH for 30 s and then rinsed in sterile distilled water. Samples of 10 g were ground and plated onto PDA + S as previously described. Colony counts were obtained after 5 days of incubation.
To observe the extent to which fungi growing on inflorescences were able to colonize stigmatic surfaces and inflorescence leaves, samples of “Watermelon Kush” and “Powdered Donuts” were harvested from these plants. The latter genotype was visibly colonized by Fusarium sporotrichiodes that grew within the inflorescence tissues from naturally derived inoculum. Tissue segments were prepared for scanning microscopy according to the method described by ref. Punja et al. (2023).
Temperature and relative humidity measurements within inflorescences
A hand-held temperature and humidity recording psychrometer (Reed 8,706 psychrometer, Reed Instruments, Newmarket, ON, Canada) was used to measure temperature and relative humidity within intact inflorescences on cannabis plants that were approaching harvest. The probe was gently inserted into the inflorescence tissues and held in place for 10 s to obtain a reading. Similar measurements were made of the surrounding environment by exposing the probe to ambient greenhouse conditions adjacent to the row of plants. Temperature and humidity measurements were recorded daily over a 2-week period during June 2021 at four different times: 6:45 a.m., 10:45 a.m., 2:45 p.m., and 6:45 p.m. Cannabis genotype “Pink Kush” was used for these measurements. Additional measurements were made at these four times over a 72-h period for two additional genotypes: “Powdered Donuts” and “Death Bubba” and compared to ambient conditions.
To investigate the influence of circulating air movement on temperature and relative humidity measurements in inflorescences, several fans were mounted above cannabis plants on central posts in the greenhouse and left on for 24 h daily over a 7-day period prior to harvest. Measurements of temperature and relative humidity were made in inflorescences of “Pink Kush” and “Powdered Donuts” under the fans, as well as on control plants not exposed to circulating air in adjacent rows of plants. The trial was conducted during August 2021 and repeated once during January 2022. Inflorescence samples (n = 5) were collected from plants grown with and without fans and TYM levels were assessed by plating as described previously.
Effects of post-harvest handling methods on TYM levels
Following harvest of cannabis inflorescences, the individual flowers (buds) may be detached from the main stem using a machine that physically strips them off (a process called bucking or destemming) (ref. Caplan et al., 2022), after which the inflorescence leaves are trimmed in a machine that passes the buds through a series of rotating blades (wet trim). The processed buds are dried on a rack on trays placed in a drying room (the wet trim, rack dry method) (ref. Caplan et al., 2022). Alternatively, the entire stem is harvested and hung upside down in the drying room, and following drying, removal of buds from stems and trimming is conducted as for wet trim (hang dry method) (ref. Caplan et al., 2022). To determine TYM levels in inflorescences that were processed by wet trim vs. hang dry, samples (total of 35) were obtained at multiple times from the same greenhouse compartment representing different genotypes to allow a comparison to be made of the resulting impact on TYM. The data from four representative samples are presented.
To estimate the impact of drying on moisture loss and TYM levels, samples of hang-dry inflorescences were taken at daily intervals over a 6-day period from a drying room. Samples were collected from 12 locations within the room and the moisture content was estimated using the method following U.S. Pharmacopeia USP 731.2
Water activity measurements were also made for each sample following the procedure of USP 922.3 TYM levels were assessed in each sample as described previously (n = 12). For each sample, four replicate Petri dishes were used and colonies were counted after 5 days of incubation at 23°C. The procedure was repeated three times using different batches of cannabis samples. The mean number of colonies for each sample was determined and expressed with the standard error of the mean (SE, n = 12).
Inflorescence samples of genotype “Pink Kush” and “Powdered Donuts” processed using the hang dry method were sent to a commercial laboratory for estimation of TYM over a 12-month period from October 2020 to September 2021, representing samples from different cropping cycles. The data from a total of 110 samples were grouped according to the reported TYM levels, which ranged from <100 to >50,000 cfu/g. Because these were individual samples obtained at various time points during the 12-month sampling period, there was no replicated data available for statistical analysis. The individual data were plotted according to frequency of samples present in each TYM category to allow comparisons to be made.
Statistical analyses
To assess whether there were significant differences among genotypes, inflorescence leaf sterilization methods, impact of air circulation, and drying methods, on TYM levels, statistical analysis was done using RStudio Version 1.3.1093. An analysis of variance (ANOVA) was used to determine significance between the means of TYM from replicated and repeated experiments in these studies. Tukey’s post-hoc test was used to determine which variables were significantly different (p < 0.05) from one another.
Results
Sampling procedures
The greenhouse environment and development of cannabis plants sampled in this study is shown in Figures 1A,B. The plants were grown in parallel rows and individually spaced about 0.5 m apart. By the time of harvest, the foliage of plants had intermingled, and the inflorescences were fully developed (Figure 1B). Each inflorescence produced multi-foliate fan leaves at the bottom with unifoliate inflorescence leaves emerging at various positions toward the top. A comparison of a fresh cannabis sample with inflorescence leaves and a dried sample in which the inflorescence leaves had been mechanically trimmed is shown in Figure 1C. These tissues were homogenized (Figure 1D) to produce a suspension that was green in color when taken from a fresh sample (Figure 1E) or brown when originating from a dried sample (Figure 1F). The resulting extract (0.5 mL) was plated onto Petri dishes containing PDA + S and spread out using a Q-tip (Figure 1G). A range of fungal colonies could be seen growing after a 5-day incubation period at 23°C (Figure 1H). The air sampling method for detecting yeasts and molds involved placing Petri dishes containing PDA + S on the plant canopy adjacent to the inflorescences at various locations in the greenhouse (Figure 1I). The colonies that emerged were numerous and diverse in morphology (Figures 1J,K) and were counted after 5 days and identified to species level using morphological and molecular methods.
Comparative morphology of cannabis genotypes
Six genotypes were grown in the same greenhouse compartment and were sampled at the same time to allow a direct comparison to be made under similar growing conditions (Figure 2). These genotypes differed in several phenotypic features that included the overall size of the inflorescences produced (height and width), density of pistils produced (as indicated by the exposed stigmatic surfaces visible on the surface), degree of compactness of the inflorescence (tight vs. loosely structured) and extent of inflorescence leaves formed (unifoliate leaves emerging directly from the inflorescence) (ref. Bernstein et al., 2019). They also differed in their susceptibility to several common diseases (Table 1). There were no differences in the range of THC or CBD levels or presence of the six most common terpenes among the genotypes. However, a correlation was observed between the relative levels of TYM present in inflorescences and the susceptibility of the same genotypes to Botrytis bud rot (ref. Mahmoud et al., 2023) and powdery mildew infection (ref. Scott and Punja, 2022) i.e., higher susceptibility to these diseases was associated with higher TYM levels in the same genotypes under similar growing conditions.
Determining total yeast and mold levels
The total number of colonies of yeast and mold present in six fresh and dried cannabis samples plated onto three different media is shown in Figures 3A,B. The standard error bars from four replicates and two duplicates of each sample showed the variation (SE) around the mean. While samples differed in the initial levels of TYM present, the different media showed similar trends. There were consistently lower TYM levels in dried samples compared to fresh samples (Figure 3B). The morphological appearance of colonies on the three-agar media after 5 days of incubation are compared in Figures 3C–E for samples identified as A, B, and E. Colonies on PDA and SDA displayed vibrant colony colors not seen on TSA. On the latter medium, colonies were mostly beige-brown in color and were indistinguishable from each other morphologically. On PDA and SDA, colonies could be identified by colony colors: green (Penicillium), yellow (Aspergillus), black (Aspergillus), and olive-brown (Cladosporium). These identifications were confirmed by PCR analysis (see below). A culture of Fusarium graminearum was plated on all three media for comparison of morphological appearance. On PDA, the colony produced a characteristic red color, which appeared yellow on SDA and white on TSA (Figure 3F). Based on these results, PDA + S was selected as the preferred medium to be included in this study for ease of identification and enumeration of colonies.
To investigate the effect of incubation temperature (23°C vs. 28°C) on TYM growth, duplicate sets of four dishes containing the three media which received extracts from homogenized fresh and dried cannabis tissues were incubated for 5 days and compared for colony numbers and visual appearance of the colonies. Colony size was greater at 28°C vs. 23°C, but overall colony number was generally lower at 28°C (Figures 4A–D). Dried tissues consistently had lower TYM levels compared to fresh tissues, as noted previously. The larger colony sizes which intermingled with each other can be seen on dishes incubated at 28°C (Figure 4E). This made it difficult to discern individual colonies compared to incubation at 23°C, which was used as the preferred incubation temperature throughout the study.
To calculate the levels of TYM present in samples (expressed as cfu/g of tissue), the amount of tissue weighed out (fresh or dried) and the dilution factor was used. Fresh tissue (10 g) or dried tissue (1 g, assumed to contain 10% moisture) were both added to 100 mL of water for blending. Following the addition of 400 mL of water and subsequent plating of 0.5 mL onto Petri dishes, the dilution factor was determined to be 1,000-fold for both fresh and dried samples. Therefore, a single colony represented 1,000 cfu/g while 10 colonies represented 10,000 cfu/g. The range of colonies observed in samples included in this study was <10,000 cfu/g (Figure 4F) to 15,000–100,000 (Figures 4G–K). The colonies were diverse in appearance and following PCR of the ITS1-5.8S-ITS2 region of rDNA, were identified primarily as Penicillium (green or whitish green colonies, Figure 4F), Cladosporium (olive-brown colonies, Figure 4G), Aspergillus spp. (black colonies [Figure 4H], or yellow colonies [Figure 4I], or olive-green colonies [Figure 4J]).
Morphological appearance of TYM colonies
A description of Aspergillus and Penicillium colonies originating from cannabis inflorescences and their spore structures as viewed in the light and scanning electron microscopes are shown in Figure 5. On PDA + S agar, Aspergillus ochraceus, A. niger, and A. flavus produced sufficiently distinct colonies on PDA + S that they could be identified using colony morphology in subsequent tissue plating analyses (Figures 5A–C). Aspergillus ochraceus was the most common species recovered in this study, appearing bright yellow on cannabis inflorescences when placed under high humidity conditions for 48 h (Figure 5D). This species, as well as all other Aspergillus species, produced spores borne in clusters (heads) on erect conidiophores (stalks) that could be seen using the scanning electron microscope (Figures 5E,F). The spore surface was spiny (echinulate) under high magnification (Figures 5G–I). In contrast, Penicillium species growing on cannabis inflorescences appeared whitish-blue (Figure 5J) and the spores were similarly produced in long chains on conidiophores and the spore surface was spiny (Figures 5K,L). In addition to these fungi, a number of yeasts were also recovered from cannabis tissues and are shown in Supplementary Figure 1.

Air sampling for yeasts and molds
Air sampling Petri dishes were used to determine the effect of leaf litter presence/absence and harvesting activity on TYM levels in the air and on inflorescences. Leaves that were removed during pruning activities were deliberately left on the greenhouse floor to dry over the 7–8 week flowering period in certain locations (Figures 6A,B), and compared to adjacent areas with no leaf litter. Inflorescences were harvested from both areas and analyzed for TYM. When these dried leaf tissues were homogenized and plated (1 g dry weight) to determine the background microbes present in them, developing colonies were identified as A. ochraceus, A. fumigatus, Penicillium, and Fusarium sp. (pink colonies; Figures 6C,D). The impact of harvesting activity, defined as the activity of workers that removed the mesh netting around plants prior to cutting and removing the inflorescence stems, as well as stepping on the dried leaves on the floor where present, on TYM in the air and on flowers, was also assessed. The data show that both the presence of leaf litter as well as the harvesting activity contributed significantly (p < 0.05) to increasing the TYM levels in the air and on flower tissues compared to where no leaf litter was present (Figures 6E,F). The Petri dishes from these studies frequently contained >100,000 cfu/g of tissue and consisted mostly of Penicillium, Aspergillus and Cladosporium species (Figure 6F). There appeared to be a seasonal effect on the TYM levels in these leaf litter experiments. When conducted during May–October compared to November–April (Figure 6G), there were more samples that exceeded the 50,000 cfu/g level in the former. These data were compiled from samples collected at various times and from different genotypes and are presented as a composite within the two sampling periods indicated.
Influence of cannabis genotypes on TYM levels
The comparative morphology and visual appearance of the inflorescence samples from six cannabis genotypes included in this study are shown in Figure 7A. When these inflorescence tissues were homogenized and plated during the months of June, July, August and September, the six genotypes were shown to contain significantly (p < 0.05) different numbers of TYM (Figure 7F) as well as diverse fungal morphologies (Figures 7B–E). In all months sampled, the most prevalent fungi were Penicillium spp., A. ochraceus, and Cladosporium spp. based on the morphology of the colonies, which was subsequently confirmed by PCR. In addition, bright pinkish-red colonies of Fusarium sporotrichiodes were seen in July and August (Figures 7C,D). The genotypes “Jack Herer” and “Death Bubba” consistently had the lowest TYM during all months of sampling (p < 0.05) (Figure 7F). The highest levels were seen on “Watermelon Kush” and “Powdered Donuts”.
Influence of inflorescence leaves of cannabis genotypes on TYM
The general appearance of a large mature inflorescence of cannabis consists of a central stalk around which aggregates of pistillate structures are produced to form a raceme, with larger 3 or 5-foliate fan leaves and smaller unifoliate inflorescence leaves emerging from all sides (Figure 2). To determine the total number of inflorescence leaves produced by different cannabis genotypes, inflorescences of genotypes “Watermelon Kush”, “Powdered Donuts”, “Jack Herer” and “Death Bubba” were obtained from greenhouse-grown plants and brought back to the laboratory. Careful dissection was performed to remove all attached leaves using a scalpel and pair of forceps. An example of a dissected inflorescence of “Powdered Donuts” and dissected leaves laid out is shown in Figure 8A. The inflorescence leaves were enumerated and the results are presented in Figure 8B. They show that there were significant differences (p < 0.05) among the four genotypes in the number of inflorescence leaves, with “Powdered Donuts” and “Watermelon Kush” having more compared to “Jack Herer” and “Death Bubba”. Following this, the fan leaves, inflorescence leaves and remaining inflorescence tissues were homogenized and plated onto PDA + S to determine TYM levels in each tissue type. The results (Figure 8C) show that the majority of TYM were associated with the inflorescence tissues and much fewer numbers were found in the inflorescence leaves and fan leaves. Genotypes “Watermelon Kush” and “Powdered Donuts” had the highest TYM (Figure 8C).

A comparison of the TYM present in inflorescence flower tissues compared to inflorescence leaves of genotypes “Watermelon Kush” and “Powdered Donuts” when plated onto PDA + S is shown in Figures 9A,B. Considerably more colonies were observed on the inflorescence flower tissues compared to the inflorescence leaves in both genotypes. When the inflorescence leaves were surface-sterilized, the TYM levels were significantly reduced in the three genotypes tested but a range of 10,000–20,000 cfu/g could still be recovered (Figure 9C). A comparison of the Petri dishes showing colonies from sterilized and unsterilized tissues from “Watermelon Kush” and “Powdered Donuts” is shown in Figures 9D,E.
Temperature and relative humidity measurements within inflorescences
The psychrometer probe, when inserted into a cannabis inflorescence for 10 s (Figure 10A), provided readings of temperature and relative humidity that were measured four times a day over a 2 week period and compared to ambient conditions measured within the row of plants (Figure 10B). The humidity within the cannabis inflorescences averaged 75% (+/− 6%) over the duration of the observations, with the highest in the morning (6:45 a.m.) and lowest in the afternoon (2:45 pm) (Figure 10B). By comparison, the daily ambient relative humidity was much lower and the fluctuations were much greater, with an average of 55% (+/− 12%); pronounced dips to as low as 45% were observed at 2:45 p.m. With regard to temperature measurements within the inflorescence, the average was 26°C (+/− 3°C), with the highest in the afternoon (2:45 p.m.) and lowest in the morning (6:45 a.m.). The average ambient temperature over the same period of measurements was 23°C (+/− 3°C); pronounced dips to as low as 19.5°C were observed at 6:45 a.m. (Figure 10B). When the temperature and relative humidity measurements were repeated for two additional genotypes (“Powdered Donuts” and “Death Bubba”) in addition to “Pink Kush” over a 3-day period, the same trends were seen for all genotypes (Figure 10C). The relative humidity and temperature measurements for ambient conditions were always much lower compared to the inflorescences. While there were some differences among the three genotypes, they were not significant when compared to ambient conditions, which were much lower (Figure 10D).

The installation of fans over plants of “Powdered Donuts” and “Pink Kush” (Figure 11A) prior to harvest to provide air circulation for 24 h daily over a one-week period resulted in a significant (p < 0.05) reduction of TYM levels in inflorescences taken from treated compared to control plants (Figure 11B). Measurements of relative humidity and temperature in inflorescences of both sets of plants showed that they were both significantly (p < 0.05) reduced due to enhanced air circulation (Figure 11B). Inflorescences from plants with fans were observed to have a waxier, shinier surface that suggested enhanced cuticular deposition on the inflorescence leaves (Figure 11C); the effect on TYM colonies growing on agar medium can be seen in Figure 11D. Fewer colonies developed from inflorescences exposed to air circulation from fans compared to the controls without fans.

Effects of post-harvest handling methods on TYM levels
Inflorescences from which individual buds were removed and subjected to a wet trim process to remove inflorescence leaves before being placed on drying racks (Figures 12A,B) were sampled for TYM analysis after 6 days of drying (Figure 12B). For comparison, inflorescences that were not removed and retained on the stem for a hang-dry method (Figures 12C,D), inclusive of a range of genotypes, were also analyzed.

Representative data from four samples are shown in Figure 13A. There was a significant (p < 0.05) reduction in TYM in all samples that were subjected to the hang-dry method compared to the wet-trim method. The appearance of colonies on PDA + S dishes after 5 days of incubation at 23°C is shown in Figures 12E,F. In all four samples, the number of colonies growing on dishes receiving homogenized extracts from wet trim samples was significantly greater compared to those receiving extracts from hang-dry samples. Most of the colonies were identified as Penicillium, Aspergillus and Cladosporium. The effect of the drying process on daily TYM levels in hang-dry inflorescences over a 6-day period is shown in Figure 13B. Following an initial increase in TYM levels during the first 3 days of drying, the populations dropped significantly to around 2,000 cfu/g on day 6. In none of the 35 samples tested was the TYM levels found to be at zero (data not shown). The impact of the drying process on the moisture content of 12 samples taken at daily intervals over 6 days from hang-dry inflorescences is shown in Figure 13C. There was a gradual but significant reduction in moisture content to an average of 12–14% (n = 48) after 6 days.

Inflorescence samples of genotype “Pink Kush” and “Powdered Donuts” processed using the hang dry method were sent to a commercial laboratory for estimation of TYM at various time points over a 12-month period from October 2020 to September 2021. A total of 110 samples were grouped according to the reported TYM levels. The data are presented according to the frequency of samples present in each category. The data in Figure 13D shows the TYM levels ranged from <100 to >50,000 cfu/g. The largest number of samples had TYM levels of 1,000–2,000 cfu/g. Only three samples out of 110 showed a TYM level close to zero, while 5 samples had TYM levels >50,000 cfu/g. When comparing genotypes “Pink Kush” and “Powdered Donuts” for TYM levels over a 12-month period, the latter genotype generally yielded samples with higher TYM levels compared to the former genotype (Figure 13D).
Discussion
The results from this study demonstrate for the first time that total yeast and mold (TYM) levels in cannabis inflorescences are significantly influenced by the genotype (strain) that is cultivated. The differences in TYM observed among six genotypes were consistent from replicated and repeated studies. Phenotypically, these genotypes differed in overall appearance, in growth rate and height, in total numbers, size, and density of inflorescences produced, and density of stigmas and trichomes (data not shown). Cannabis genotypes are known to differ significantly in the levels of cannabinoids and terpenes produced (ref. Schwabe and McGlaughlin, 2019; ref. Zager et al., 2019), and display different organoleptic properties in the final product that reflect these differences in chemical composition (chemotype). While this is the first report demonstrating that genotypic differences can affect microbial levels within cannabis inflorescences, in other plant species, phytobiome composition has been reported to be affected by host genetic composition (ref. Whipps et al., 2008; ref. Qian et al., 2018; ref. Singer et al., 2021). As stated by ref. Singer et al. (2021): “genetic differences within a given plant species can affect microbe recruitment, community assembly, and ultimately the composition of phytobiomes. As such, the phytobiome can be considered an extended phenotype of the plant that is determined by host genetics, the environment, and their complex interaction.” Our results highlight the importance of genotypic differences among cannabis plants which can influence the extent of microbial colonization of inflorescences.
The density of inflorescence leaves on different cannabis genotypes, which collectively created a warmer and more humid microclimate within the inflorescences, was shown to enhance TYM levels. This is supported by three lines of evidence. First, relative humidity and temperature measurements made within the inflorescences of three genotypes showed they were significantly higher compared to the ambient environment, pointing to the importance of the microclimate created by these leaves. Second, a negative impact on TYM populations was observed by enhanced air circulation using fans blowing over the plants, which reduced both the temperature and relative humidity within the inflorescences. This drier environment created by enhanced air circulation was observed to reduce microbial growth. Third, the overall levels of TYM in cannabis samples were consistently lower following post-harvest drying compared to fresh samples, reflecting the importance of moisture in enhancing TYM growth and survival. In hop flowers, the drying process was shown to reduce the overall microbial populations by up to 75% (ref. Allen et al., 2019). Inflorescence leaves are metabolically active and contain abundant glandular trichomes and can manufacture up to 50% of the THC and CBD found in the inflorescence (ref. Bernstein et al., 2019). The density of inflorescence leaves differed significantly among four cannabis genotypes studied, and a proportion of the TYM was found to reside in the inflorescence leaves themselves, even after surface-sterilization, suggesting they were internalized as endophytes. However, the majority of TYM resided as epiphytes, and were recovered by homogenizing tissues briefly before plating. The predominant fungi recovered were Penicillium, Aspergillus, and Cladosporium species, which are commonly present in the greenhouse environment (ref. Punja et al., 2019).
The importance of trichomes, which are produced in abundance on bracts and inflorescence leaves on cannabis inflorescences (ref. Punja et al., 2023), in supporting these microbial communities and/or permitting ingress by plant pathogens, has not been determined. On tomato leaves, trichomes produced on two different genotypes supported specific trichome-associated bacterial communities (ref. Kusstatscher et al., 2007). In other plant species, trichomes served as habitats for microbes and potentially also provided sites for infection by plant pathogens (ref. Kim, 2019). In addition to these interactions, trichomes potentially also provided sites for establishment of endophytic relationships with fungi (ref. Kim, 2019). These types of trichome-microbe interactions have not been studied within cannabis inflorescences and can provide a better understanding of how these microbial populations become established. The ecological role of these microbes in potentially providing protection to the inflorescences from invasion by other fungi through competition was demonstrated through in vitro antagonism tests against several plant pathogenic fungi in this study (Supplementary Figure 2). Flowers of many plant species naturally contain a range of fungal, bacterial and yeast species with important ecological roles, including exerting competition against other microbes (ref. Berg et al., 2017; ref. Gouka et al., 2022). For example, a common cannabis epiphyte and endophyte, P. olsonii (ref. Punja et al., 2019; ref. Punja, 2021b), was recently demonstrated to colonize wheat spikes and induce transient expression of plant defense genes, which resulted in a reduction of Fusarium head blight development caused by F. graminearum (ref. Rojas et al., 2022). Any potentially positive attributes of microbial colonizers of cannabis inflorescences deserve further attention.
Another feature of cannabis plants that can promote a build-up of TYM within inflorescences is the density of pistils (consisting of stigma, style and ovary tissues) and larger sizes of inflorescences observed in certain genotypes, such as “Watermelon Kush” and “Powdered Donuts”, that harbored consistently high TYM levels. Scanning electron microscopic observations showed that mycelium ramified over the pistils (in particular the stigmatic tissues) as well as the trichomes (Supplementary Figure 3). Pistils can provide sites on which bacterial and fungal populations can establish within flowers (ref. Gschwend et al., 2021). A microbiome study of apple flowers, focused on the stigmatic tissues, showed that a diverse bacterial community was present, which could exert antagonistic activity against apple pathogens (ref. Cui et al., 2021). In other plant species, such as pepper and wheat, stigmatic tissues provided infection sites for pathogenic fungi (ref. Yang et al., 2010; ref. Reis et al., 2016). A number of Fusarium species are reported to infect cannabis through a similar point of entry (ref. Punja, 2021c), indicating the importance of stigmatic tissues in providing access to pathogens and TYM. Microbiome studies of the inflorescence tissues of cannabis should provide useful insights into the microbial communities, similar to what has been described from hop flowers (anthosphere microbiome) (ref. Allen et al., 2019) and also in different tissue compartments within hemp plants (ref. Barnett et al., 2020; ref. Ahmed et al., 2021; ref. Wei et al., 2021) and cannabis plants (ref. Comeau et al., 2020). These studies would shed light on the temporal colonization of cannabis inflorescences as a function of genotype, environment and other factors, potentially leading to a better understanding of how TYM populations become established. Among the six genotypes included in this study, those that had a higher frequency of TYM levels in the inflorescences also appeared to show higher susceptibility to two pathogens of cannabis, namely powdery mildew and Botrytis bud rot. The range of levels of terpenes, THC or CBD among these genotypes did not correlate with a build-up of TYM.
Leaf litter left on the greenhouse floor after pruning activities harboured a range of fungi and yeasts, as shown by plating assays, the most prevalent of which were species of Aspergillus, Cladosporium and Penicillium. Leaves harbor a significant population of microbes at various stages of decomposition (ref. Voříšková and Baldrian, 2013; ref. Purahong et al., 2016). Harvesting activity, wherein workers remove foliage and prepare inflorescence stems for manual harvest, and step on the leaf litter, caused a significant increase in air-borne propagules of TYM, which were detected on air sampling plates. Cannabis inflorescences at harvest are sticky to the touch due to the secretion of resinous compounds from trichomes (ref. Andre et al., 2016); spores of various fungi can adhere to the surfaces of stigmas and trichomes (ref. Punja and Ni, 2021; ref. Scott and Punja, 2022; ref. Punja and Scott, 2023) and may be recovered on PDA + S medium. Subsequently, higher propagules of airborne fungi and yeasts can lead to higher TYM contamination. More fungal propagules would be expected to be present during the summer months compared to winter months (ref. Punja et al., 2019); this could in part explain the higher incidence of TYM in samples collected during May–September compared to October–April in this study. A larger number of samples exceeded the 50,000 cfu/g limit in the former period compared to the latter.
In comparing PDA + S to Sabouraud dextrose and tryptic soy agars in this study, colonies on PDA + S were morphologically distinct and easier to identify and enumerate. ref. McKernan et al. (2021) reported that potato dextrose agar amended with chloramphenicol provided the highest numbers and greatest diversity of fungal colonies from cannabis tissue samples compared to other agar media. Incubation of Petri dishes at 23°C provided more consistent colony size in the present study compared to the faster growing, and hence larger, intermingling colonies on dishes incubated at 28°C. An incubation period of 5 days under 10–14 h light was required to ensure colonies had reached a size that could be counted. ref. Repay (2021) observed consistent and high recovery of TYM on Petrifilm™ medium. ref. Schumacher et al. (2022) observed greater morphological diversity of colonies when dishes were incubated at 25°C compared to 28°C, confirming that temperatures of 22–25°C are more suited for TYM growth.
Assessments of TYM in cannabis samples conducted by commercial laboratories may deploy a wide range of methods (ref. Curry, 2022), which were not evaluated in our study. We instead focused on aspects of cannabis production methods that could affect TYM build-up during growth. When compared to the results for the same samples sent to two commercial laboratories, our method showed colony counts that were 7–22% greater than reported from one laboratory (lab A) and significantly higher (by up to 76%) than from a second laboratory (lab B) (Supplementary Table 1). The methods used by these laboratories are unknown, but lab B results may have greatly under-represented actual TYM levels. We homogenized samples, without pre-incubation, briefly (30 s) without the addition of buffers or reagents (in water) and rated colonies after 5 days at 23–25°C and 10–14 h light. These conditions may allow for a greater recovery of TYM compared to other approaches, but further research is needed to identify such variables. Discrepancies between commercial laboratories in TYM test results can be concerning from a regulatory perspective, since some cannabis samples reaching the consumer may contain higher levels of TYM than actually reported, depending on the laboratory performing the testing (ref. Pusiak et al., 2021; ref. Curry, 2022). The need for a universally adopted standardized method for TYM testing in the cannabis industry has been recognized (ref. Curry, 2022; ref. Jameson et al., 2022). Utilizing molecular-based qPCR analysis can identify specific subsets of TYM of concern to human health (ref. Leppanen et al., 2019; ref. McKernan et al., 2021). At present, all fungi and yeasts present in a cannabis sample, including those considered to be beneficial and approved for use during production by regulatory agencies and deemed to be safe for humans, are included in TYM assessment. For example, the application of biocontrol fungi, such as Trichoderma and Gliocladium, during cannabis production can increase TYM at harvest (Supplementary Figure 4), potentially causing them to fail under current regulatory requirements. A summary of the factors that can impact microbial presence in cannabis inflorescences is shown in Figure 14.

In addition to fungi, four yeast genera were recovered in this study – Pseudozyma, Rhodotorula, Meyerozyma (Pichia) and Candida – which are widely distributed and present in various environments and on a range of plant species (ref. Fernandez et al., 2012; ref. Wirth and Goldani, 2012; ref. Gafni et al., 2015; ref. Gouka et al., 2022). They have not been previously reported from cannabis inflorescences and may constitute a component of the anthosphere. Epiphytic yeasts utilize a wide variety of nutrient sources and colonize a range of plant surfaces (ref. Gafni et al., 2015). For example, P. aphidis (syn. Moesziomyces aphidis) (ref. Kruse et al., 2017) was isolated from aphid secretions, produces extracellular polysaccharides and lipids (ref. Lorenz et al., 2014) and occupies the same niches as pathogens such as powdery mildew (Podosphaeria xanthii) and gray mold (Botrytis cinerea) while secreting chitinase enzymes that contributed to its biocontrol activity on cucumber plants (ref. Gafni et al., 2015). Rhodotorula mucilaginosa produces the siderophore rhodotorulic acid (ref. Andersen et al., 2003), which showed in vitro suppressive effects against a number of fungi commonly found in cannabis inflorescences, including Botrytis, Cladosporium, Penicillium and Rhizopus (ref. Calvente et al., 2001). However, Rhodotorula spp. have been considered as potential opportunistic yeast pathogens of humans under specific circumstances (ref. Wirth and Goldani, 2012). Pseuodozyma aphidis demonstrated biological control activity against powdery mildew fungi (ref. Gafni et al., 2015), potentially providing a benefit to the cannabis plant. Similarly, Tilletiopsis spp. present in hemp inflorescences were suggested to provide resident biocontrol activity (ref. Barnett et al., 2020). Pichia and Candida species were recovered at a much lower frequency from cannabis inflorescences in this study and their potential importance remains undetermined.
Commercial drying of cannabis inflorescences is performed in specially designed drying rooms over a 5–7 day period at 21–23°C and 40–55% relative humidity (ref. Caplan et al., 2022). These conditions ensure a slow removal of moisture to a final content of 12–14%, equating to a water activity of 0.65–0.7 (ref. Caplan et al., 2022). Two general methods for handling cannabis inflorescences post-harvest are: (i) rack (screen) drying, where individual buds are mechanically removed from the stem followed by mechanical trimming of the inflorescence leaves (wet trim) and then dried, and (ii) hang-dry, where entire stems are hung upside down with leaves attached followed by trimming the inflorescence leaves after drying (ref. Caplan et al., 2022). In a previous study (ref. Punja et al., 2019), wet trim was reported to cause injury to inflorescence leaves that resulted in a significant build-up of microbial populations post-harvest. In the present study, a comparison of wet trim and hang dry processes showed that TYM in samples processed using the hang-dry method were significantly lower. The absence of injury sites for colonization by resident or introduced microbes in trimmed dried samples compared to trimmed fresh samples would account for the difference between the two handling methods.
During the hang dry process, the foliage present on the stems (see Figures 12C,D) caused a spike in TYM during the first 72 h. The air in the drying rooms also showed a significant increase in the population of air-borne propagules, likely to have originated from the leaf tissues (data not shown). Leaves can harbour a significant population of microbes at various stages of decomposition (ref. Voříšková and Baldrian, 2013; ref. Purahong et al., 2016). Upon further drying to 96 h, the TYM levels were significantly reduced as the tissue moisture content was reduced to 12–14%. During moisture removal, microbial populations rapidly decline since drier conditions are unfavorable for growth of most yeasts and molds, which occurs optimally at water activities (aw) near 0.9 (ref. Beuchat, 1983). The minimum aw at which growth of fungi has been observed is around 0.61 (ref. Beuchat, 1983). However, certain species of yeasts and fungi, can grow and survive at a w of 0.62–0.7. These xerotolerent microbes, which include species of Aspergillus and Penicillium, were commonly present in cannabis inflorescences in this study. Cannabis products with a water activity >0.70 aw but less than 0.86 aw are considered shelf-stable but will still support the growth of molds and yeasts (ref. Carter, 2019). Our data showed that even after 6 days of drying to a moisture content of 12–14% (translating to aw of ca. 0.62–0.7), there were still remnants of microbial activity that could be detected on plating media. Inadequate drying of cannabis samples that leave pockets of moisture can result in a higher survival rate of TYM. In subsequent handling processes, such as curing, storage and shipping, a proliferation of these residual microbes could take place. As a step toward totally eliminating TYM in dried cannabis samples, the use of electron-beam irradiation was shown to reduce microbial activity in treated samples to undetectable levels (ref. Punja, 2021b). While deemed to be an effective method to eliminate TYM in cannabis (ref. Jerushalmi et al., 2020; ref. Dhillon et al., 2022), it is a costly process and does not eliminate mycotoxins (ref. Khaneghah et al., 2020; ref. Akhila et al., 2021). Also, it is not approved for use in all jurisdictions and the impact on levels of cannabinoids and terpenes has not been well established.
The 12-month study quantifying the TYM levels in two cannabis genotypes (“Pink Kush” and “Powdered Donuts”) that were processed using the hang dry method showed that from 110 samples, the largest number contained TYM levels of 1,000–2,000 cfu/g. Only three samples had a TYM level close to zero, while 5 samples out of 110 had TYM levels >50,000 cfu/g. This indicates that the majority of greenhouse-grown cannabis tissues generally contain a low frequency of TYM, and the extent to which they may proliferate could be influenced by the genotype and/or post-harvest handling and storage conditions. In comparing “Pink Kush” and “Powdered Donuts” for TYM levels over the 12-month period, the latter genotype generally yielded more samples with higher TYM levels compared to the former genotype, confirming previous observations from this study on genotypic differences.
TYM testing of cannabis products follows protocols established from the food industry, where contamination by yeasts and molds can lead to severe food-borne illnesses and poor quality of product (ref. Tournas et al., 2001; ref. Boyar, 2021). Since cannabis is not directly ingested, but rather inhaled or vaped or further extracted and utilized, it seems reasonable that the presence of, and potential threat to humans, of specific microbes and their by-products, such as mycotoxins, should be assessed. For example, the two most prevalent species of Aspergillus observed in this study – A. ochraceus and A. niger—are both known to produce Ochratoxin A (OTA), in addition to Penicillium spp. OTA is a nephrotoxic and carcinogenic agent commonly found in a range of fungal-contaminated agricultural products (ref. Moss, 2008; ref. Pitt and Hocking 2009b; ref. Malir et al., 2016; ref. Atumo, 2020). A number of jurisdictions, including the state of California, require mandatory testing for four Aspergillus spp. (ref. Boyar, 2021; ref. Jameson et al., 2022). Yet, surprisingly, A. ochraceus, the most commonly recovered fungus from inflorescences and leaves of greenhouse-grown cannabis in the present study, is not mentioned in previous reports of fungi of concern to human health present in cannabis tissues (ref. Leppanen et al., 2019; ref. Boyar, 2021; ref. McKernan et al., 2021). This species, as well as A. niger, are widely distributed, and are present in dried foods, including dried fish, various dried beans and pulses, nuts and oilseeds (ref. Pitt and Hocking, 1997; ref. Pitt and Hocking, 2009a). The presence of both species in grapes and green coffee beans may lead to ochratoxin A production (ref. Mantle and Chow, 2000; ref. Perrone et al., 2007; ref. Pitt and Hocking, 2009a; ref. Pandit et al., 2014). Neither species is currently included for specific testing in cannabis, nor are Fusarium spp., although these fungi are known to produce a range of mycotoxins and both are frequently present in cannabis inflorescences (ref. Punja, 2021c; ref. Gwinn et al., 2022). In addition, up to 34 different fungal species can be recovered from dried cannabis samples in commercial facilities to varying degrees (ref. Punja, 2021b). Mycotoxin production is affected by water activity, and generally fungal growth at aw of 0.83–0.9 is required (ref. Beuchat, 1983). Most rapid colonization of cannabis inflorescences by potential mycotoxin-producing fungi would likely occur during inflorescence growth prior to harvest (ref. Punja, 2021c) and subsequent drying to aw values of 0.62–0.7 would not impact any mycotoxin accumulation that has already occurred. This highlights the importance of pre-harvest monitoring and management of inflorescence-contaminating fungi to reduce their potential impact on cannabis consumers. A re-examination of the fungal and yeast species considered by regulatory agencies to pose a threat to consumers of cannabis would seem prudent. Many identified in this study are not considered harmful, yet would be included in current TYM testing regulations.
Conclusion
Our results highlight the various factors which can cause a build-up of TYM to occur in inflorescences during cannabis production. We have also identified some of the variables that can potentially cause samples to fail to meet regulatory standards due to excessive TYM. However, different cfu/g limits set by different jurisdictions make it challenging for cannabis producers. In different states within the USA, for example, acceptable levels of TYM differ significantly.4 In countries such as Canada, where cannabis is approved for medicinal and recreational use, the guidelines are uniform (ref. Health Canada, 2019; ref. Pusiak et al., 2021). The inconsistencies in cannabis product testing between different laboratories raises an ongoing concern, and the development of standardized methods for quantifying TYM needs to be addressed by regulatory agencies to ensure there is consistent product quality for the consumer, as stated by ref. Jameson et al. (2022). Not all species of TYM present in cannabis inflorescences pose potential harm to humans; some have been demonstrated to have antifungal activity against deleterious plant pathogens of cannabis and may be exerting a natural form of biological control often reported in other plant species. Distinguishing between those yeasts and molds that are beneficial from those that are harmful will continue to present a challenge, since the majority of current testing protocols rely solely on an analysis of total colony-forming units. Species-specific molecular testing can be one approach to address this issue. The results from this study identify avenues for producers to monitor and manage the potential build-up of TYM in fresh and dried cannabis samples that should lead to lower TYM and a higher quality product. This study has emphasized greenhouse grown cannabis. Other production systems, such as field-grown or organically grown cannabis, also need to be assessed, as there can be differences in the amount and types of TYM present (ref. Punja and Scott, 2023).
Data availability statement
The original contributions presented in the study are included in the article/Supplementary material, further inquiries can be directed to the corresponding author.
Author contributions
ZP conducted the design of experiments, development of methods, collection of data, supervision of the project, preparation of figures, and writing of the manuscript. LN conducted the experiments on TYM plating. SL and LB conducted the collection of samples from the greenhouse and drying rooms and associated measurements and analysis. All authors contributed to editing of the manuscript and finalization of figures for publication.
Funding
This research was jointly funded by an Alliance Grant from the Natural Sciences and Engineering Research Council of Canada (NSERC) (grant number 571270–21) and industry funding from Pure Sunfarms. Additional funding was provided by the B.C. Ministry of Agriculture/Agriculture and Agri-Food Canada through the Canadian Agricultural Partnership (CAP) Program Project No. URACP 19–212.
Conflic of interest
The authors declare that the research was conducted in the absence of any commercial or financial relationships that could be construed as a potential conflict of interest.
Publisher’s note
All claims expressed in this article are solely those of the authors and do not necessarily represent those of their affiliated organizations, or those of the publisher, the editors and the reviewers. Any product that may be evaluated in this article, or claim that may be made by its manufacturer, is not guaranteed or endorsed by the publisher.
References
- B. Ahmed, L. B. Smart, M. Hijri. Microbiome of field grown hemp reveals potential microbial interactions with root and rhizosphere soil.. Front. Microbiol., 2021. [DOI | PubMed]
- P. P. Akhila, K. V. Sunooj, B. Aaliya, M. Navaf, C. Sudheesh, S. Sabu. Application of electromagnetic radiations for decontamination of fungi and mycotoxins in food products: A comprehensive review.. Trends Food Sci. Technol., 2021. [DOI]
- M. E. Allen, A. J. Piefer, S. N. Cole, J. J. Werner, P. T. Benziger, L. Grieneisen. Characterization of microbial communities populating the inflorescences of Humulus lupulus L.. J. Amer. Soc. Brewing Chem., 2019. [DOI]
- D. Andersen, J. C. Renshaw, M. G. Wiebe. Rhodotorulic acid production by Rhodotorula mucilaginosa.. Mycol. Res., 2003. [DOI | PubMed]
- C. M. Andre, J. F. Hausman, G. Guerriero. Cannabis sativa: the plant of the thousand and one molecules.. Front. Plant Sci., 2016. [DOI | PubMed]
- Committee on herbal medicinal products. Guideline on specifications: test procedures and acceptance criteria for herbal substances, herbal preparations and herbal medicinal products / traditional herbal medicinal products.. 2018
- S. Atumo. A review of Ochratoxin A occurrence, condition for the formation and analytical methods.. Inter. J. Agric. Sci. Food Technol., 2020. [DOI]
- S. E. Barnett, A. R. Cala, J. L. Hansen, J. Crawford, D. R. Viands, L. B. Smart. Evaluating the microbiome of hemp.. Phytobiomes J., 2020. [DOI]
- G. Berg, M. Koberl, D. Rybakova, H. Muller, R. Grosch, K. Smalla. Plant microbial diversity is suggested as the key to future biocontrol and health trends.. FEMS Microbiol. Ecol., 2017. [DOI]
- N. Bernstein, J. Gorelick, S. Koch. Interplay between chemistry and morphology in medical cannabis (Cannabis sativa L.).. Indust. Crops Products, 2019. [DOI]
- L. R. Beuchat. Influence of water activity on growth, metabolic activities and survival of yeasts and molds.. J. Food Prot., 1983. [DOI | PubMed]
- K. Boyar. Cannabis microbial testing – methodologies and considerations”. In. Recent advances in the science of Cannabis. eds. R. M. Strongin, J. Meehan-Atrash, M. Vialpando, 2021
- V. Calvente, M. De Orellano, G. Sansone, D. Benuzzi, M. S. De Tosetti. Effect of nitrogen source and pH on siderophore production by Rhodotorula strains and their application to biocontrol of phytopathogenic moulds.. J. Industr. Microbiol. Biotech., 2001. [DOI | PubMed]
- D. Caplan, P. Matzneller, D. Gutierrez. Harvest and post-harvest” in. Handbook of cannabis production in controlled environments. ed., 2022
- B. P. Carter. The what, why and how of water activity in cannabis.. Cannabis Sci. Tech., 2019
- D. Comeau, A. Novinscak, D. L. Joly, M. Filion. Spatio-temporal and cultivar-dependent variations in the cannabis microbiome.. Front. Microbiol., 2020. [DOI | PubMed]
- Z. Cui, R. B. Huntley, N. P. Schultes, B. Steven, Q. Zeng. Inoculation of stigma-colonizing microbes to apple stigmas alters microbiome structure and reduces the occurrence of fire blight disease.. Phytobiomes J., 2021. [DOI]
- J Curry. The benefits and pitfalls of total yeast and mold counts in cannabis labs.. 2022
- G. S. Dhillon, S. Hukkeri, D. Nightingale, J. Callaway. Evaluation of different techniques to decontaminate medical cannabis and their effect on cannabinoid content.. ACS Agric. Sci. Technol., 2022. [DOI]
- N. V. Fernandez, M. C. Mestre, P. Marchelli, S. B. Fontenla. Yeast and yeast-like fungi associated with dry indehiscent fruits of Nothofagus nervosa in Patagonia.. Argentina. FEMS Microbiol. Ecol., 2012. [DOI | PubMed]
- A. Gafni, C. E. Calderon, R. Harris, K. Buxdorf, A. Dafa-Berger, E. Zeilinger-Reichert. Biological control of the cucurbit powdery mildew pathogen Podosphaera xanthii by means of the epiphytic fungus Pseudozyma aphidis and parasitism as a mode of action.. Front. Plant Sci., 2015. [DOI | PubMed]
- L. Gouka, J. M. Raaijmakers, V. Cordovez. Ecology and functional potential of phyllosphere yeasts.. Trends Plant Sci., 2022. [DOI | PubMed]
- F. Gschwend, A. Braun-Kiewnick, F. Widmer, C. Pelludat. Apple blossoms from a Swiss orchard with low-input plant protection regime reveal an abundance of potential fire blight antagonists.. Phytobiomes J., 2021. [DOI]
- K. D. Gwinn, Z. Hansen, H. Kelly, B. H. Ownley. Diseases of Cannabis sativa caused by diverse Fusarium species.. Front. Agron., 2022. [DOI]
- Guidance document: Good production practices guide for cannabis. 2019
- L. E. Jameson, K. D. Conrow, D. V. Pinkhasova, H. L. Boulanger, H. Ha, N. Jourabchian. Comparison of state-level regulations for cannabis contaminants and implications for public health.. Environ. Health Perspect., 2022. [DOI]
- S. Jerushalmi, M. Maymon, A. Dombrovsky, S. Freeman. Effects of cold plasma, gamma and e-beam irradiations on reduction of fungal colony forming unit levels in medical cannabis inflorescences.. J. Cannabis Res., 2020. [DOI | PubMed]
- M. A. Khaneghah, H. M. Moosavi, C. A. F. Oliveira, F. Vanin, A. S. Sant’Ana. Electron beam irradiation to reduce the mycotoxin and microbial contaminations of cereal-based products: an overview.. Food Chemical Toxicol., 2020. [DOI | PubMed]
- K. W. Kim. Plant trichomes as microbial habitats and infection sites.. Eur. J. Plant Path., 2019. [DOI]
- J. Kruse, G. Doehlemann, E. Kemen, M. Thines. Asexual and sexual morphs of Moesziomyces revisited.. IMA Fungus, 2017. [DOI | PubMed]
- P. Kusstatscher, W. A. Wicaksono, A. Bergna, T. Cernava, N. Bergau, A. Tissier. Trichomes form genotype-specific microbial hotspots in the phyllosphere of tomato.. Environ Microbiome, 2007. [DOI]
- S. D. Leppanen, H. Ebling, A. Macherone. Optimized cannabis microbial testing: combined use of extraction methods and pathogen detection tests using quantitative polymerase chain reaction.. Cannabis Sci. Tech., 2019
- S. Lorenz, M. Guenther, C. Grumaz, S. Rupp, S. Zibek, K. Sohn. Genome sequence of the basidiomycetous fungus Pseudozyma aphidis DSM70725, an efficient producer of biosurfactant mannosylerythritol lipids.. Genome Announc., 2014. [DOI | PubMed]
- M. Mahmoud, I. BenRejeb, Z. K. Punja, L. Buirs, S. Jabaji. Understanding bud rot development, caused by Botrytis cinerea, on cannabis (Cannabis sativa L.) plants grown under greenhouse conditions.. Botany, 2023
- F. Malir, V. Ostry, A. Pfohl, J. Malir, J. Toman. Ochratoxin A: 50 years of research.. Toxins, 2016. [DOI | PubMed]
- P. G. Mantle, A. M. Chow. Ochratoxin formation in Aspergillus ochraceus with particular reference to spoilage of coffee.. Int. J. Food Microbiol., 2000. [DOI | PubMed]
- K. McKernan, Y. Helbert, L. Kane, N. Houde, L. Zhang, S. McLaughlin. Whole genome sequencing of colonies derived from cannabis flowers and the impact of media selection on benchmarking total yeast and mold detection tools.. F1000 Research, 2021. [DOI | PubMed]
- M. O. Moss. Fungi, quality and safety issues in fresh fruits and vegetables.. J. Appl. Microbiol., 2008. [DOI | PubMed]
- E. Naim-Feil, E. J. Breen, L. W. Pembleton, L. E. Spooner, G. C. Spangenberg, N. O. I. Cogan. Empirical evaluation of inflorescences’ morphological attributes for yield optimization of medicinal cannabis cultivars.. Front. Plant Sci., 2022. [DOI | PubMed]
- P. Pandit, O. P. Panta, T. B. Karki. Isolation of Aspergillus ochraceus and production of ochratoxin in coffee samples.. Nepal J. Sci. Technol., 2014
- G. Perrone, A. Susca, G. Cozzi, K. Ehrlich, J. Varga, J. C. Frisvad. Biodiversity of Aspergillus species in some important agricultural products.. Stud. Mycol., 2007. [DOI | PubMed]
- J.I. Pitt, A.D. Hocking. Fungi and food spoilage., 1997
- J. I. Pitt, A. D. Hocking. Aspergillus and related teleomorphs” in. Fungi and food spoilage., 2009a
- J. I. Pitt, A. D. Hocking. Penicillium and related genera” in. Fungi and food spoilage., 2009b
- Z. K. Punja. Emerging diseases of Cannabis sativa and sustainable management.. Pest Manag. Sci., 2021a. [DOI | PubMed]
- Z. K. Punja. The diverse mycoflora present on dried cannabis (Cannabis sativa L., marijuana) inflorescences in commercial production.. Can. J. Plant Pathol., 2021b. [DOI]
- Z. K. Punja. Epidemiology of Fusarium oxysporum causing root and crown rot of cannabis (Cannabis sativa L., marijuana) plants in commercial greenhouse production.. Can. J. Plant Pathol., 2021c. [DOI]
- Z. K. Punja, D. Collyer, C. Scott, S. Lung, S. J. Holmes. Pathogens and molds affecting production and quality of Cannabis sativa L.. Front. Plant Sci., 2019. [DOI | PubMed]
- Z. K. Punja, L. Ni. The bud rot pathogens infecting cannabis (Cannabis sativa L., marijuana) inflorescences: symptomology, species identification, pathogenicity and biological control.. Can. J. Plant Pathol., 2021. [DOI]
- Z. K. Punja, C. S. Scott. Organically grown cannabis (Cannabis sativa L.) plants contain a diverse range of culturable epiphytic and endophytic fungi in inflorescences and stem tissues.. Botany. doi:, 2023. [DOI]
- Z. K. Punja, D. S. Sutton, T. Kim. Glandular trichome development, morphology, and maturation are influenced by plant age and genotype in high THC-containing cannabis (Cannabis sativa L.) inflorescences.. J. Can. Res., 2023. [DOI | PubMed]
- W. Purahong, T. Wubet, G. Lentendu, M. Schloter, M. J. Pecyna, D. Kapturska. Life in leaf litter: novel insights into community dynamics of bacteria and fungi during litter decomposition.. Mol. Ecol., 2016. [DOI | PubMed]
- R. J. P. Pusiak, C. Cox, C. S. Harris. Growing pains: an overview of cannabis quality control and quality assurance in Canada.. Int. J. Drug Policy, 2021. [DOI | PubMed]
- X. Qian, T. Duan, X. Sun, Y. Zheng, Y. Wang, M. Hu. Host genotype strongly influences phyllosphere fungal communities associated with Mussaenda pubescens var. alba (Rubiaceae).. Fungal Ecol., 2018. [DOI]
- E. M. Reis, C. Boarelo, A. L. D. Danelli, S. M. Zoldan. Anthesis, the infectious process and disease progress curves for fusarium head blight in wheat.. Summa Phytopathol., 2016. [DOI]
- A. J. Repay. Temperature comparison of 3M rapid yeast and Mold Petrifilm using manufacturer’s suggested temperatures on dried cannabis flower (Cannabis spp.).. Cannabis Sci. Tech., 2021
- E. C. Rojas, B. Jensen, H. J. L. Jørgensen, M. A. C. Latz, P. Esteban, D. B. Collinge. The fungal endophyte Penicillium olsonii ML37 reduces Fusarium head blight by local induced resistance in wheat spikes.. J. Fungi, 2022. [DOI | PubMed]
- A. Schumacher, C. Lingle, K. M. Silbernagel. 3M™ Petrifilm™ rapid yeast and Mold count plate for the enumeration of yeasts and molds in dried cannabis flower: AOAC® official method 2014.05.. J. AOAC Int., 2022. [DOI | PubMed]
- A. L. Schwabe, M. E. McGlaughlin. Genetic tools weed out misconceptions of strain reliability in Cannabis sativa: implications for a budding industry.. J. Cannabis Res., 2019. [DOI | PubMed]
- C. Scott, Z. K. Punja. Management of diseases on cannabis in controlled environment production” in. Handbook of cannabis production in controlled environments. ed., 2022
- E. Singer, J. P. Vogel, T. Northen, C. J. Mungall, T. E. Juenger. Novel and emerging capabilities that can provide a holistic understanding of the plant root microbiome.. Phytobiomes J., 2021. [DOI | PubMed]
- V. Tournas, M.E. Stack, P.B. Mislivec, H.A. Koch, R. Bandler. Bacteriological analytical manual. Chapter 18. Yeasts, molds and mycotoxins. US Food and Drug Administration. 2001
- J. Voříšková, P. Baldrian. Fungal community on decomposing leaf litter undergoes rapid successional changes.. ISME J., 2013. [DOI | PubMed]
- G. Wei, K. Ning, G. Zhang, H. Yu, S. Yang, F. Dai. Compartment niche shapes the assembly and network of Cannabis sativa-associated microbiome.. Front. Microbiol., 2021. [DOI | PubMed]
- J. M. Whipps, P. Hand, D. Pink, G. D. Bending. Phyllosphere microbiology with special reference to diversity and plant genotype.. J. Appl. Microbiol., 2008. [DOI | PubMed]
- F. Wirth, L. Z. Goldani. Epidemiology of Rhodotorula: an emerging pathogen.. Interdiscipl. Perspect. Infect. Dis., 2012. [DOI | PubMed]
- Y. Yang, T. Cao, J. Yang, R. J. Howard, P. D. Kharbanda, S. E. Strelkov. Histopathology of internal fruit rot of sweet pepper caused by Fusarium lactis.. Can. J. Plant Path., 2010. [DOI]
- J. J. Zager, I. Lange, N. Srividya, A. Smith, B. M. Langea. Gene networks underlying cannabinoid and terpenoid accumulation in Cannabis.. Plant Physiol., 2019. [DOI | PubMed]
